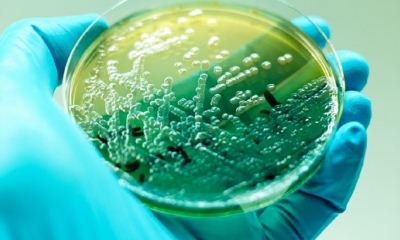
foto28990-4

Recomendaciones de propietarios de casas particulares, cómo garantizar eliminar el olor del tanque séptico.
 La vida cómoda en una casa privada requiere la disposición de un tanque séptico que procesa los desechos domésticos. Pero los errores de conexión y funcionamiento pueden provocar un olor muy desagradable.
La vida cómoda en una casa privada requiere la disposición de un tanque séptico que procesa los desechos domésticos. Pero los errores de conexión y funcionamiento pueden provocar un olor muy desagradable.
El diagnóstico oportuno del problema y un método de solución seleccionado correctamente eliminarán rápidamente los olores desagradables del tanque séptico, lo que devolverá una vida cómoda en una casa privada.
Le diremos cómo eliminar el olor de un tanque séptico en una casa privada en el artículo.
Contenido
¿Qué es lo primero que debes hacer?
 Para identificar la causa del olor desagradable y tomar medidas adicionales para eliminarlo, En primer lugar, es necesario conocer los siguientes puntos:
Para identificar la causa del olor desagradable y tomar medidas adicionales para eliminarlo, En primer lugar, es necesario conocer los siguientes puntos:
- la duración de la limpieza del tanque séptico;
- la presencia de un elevador de ventilación;
- análisis de daños a tuberías de alcantarillado;
- la probabilidad de descargar agua que contiene químicos agresivos, detergentes en el alcantarillado;
- términos de llenado del tanque séptico con bacterias anaeróbicas.
Una vez que se haya recibido la respuesta a las preguntas básicas, no será difícil seleccionar un método para eliminar la causa del olor desagradable.
Razones de la aparición de un olor desagradable.
Hay varias razones por las que se interrumpe el funcionamiento ininterrumpido del tanque séptico:
- Problemas de ventilación, provocados por errores de diseño e instalación, falta de tubería de drenaje.
- Problemas con las tuberías de alcantarillado (fugas en las juntas, tuberías de plástico agrietadas).
- Incapacidad de las bacterias anaeróbicas para procesar eficazmente las aguas residuales. Esta situación ocurre cuando el volumen de efluente es varias veces mayor que la capacidad de procesamiento de las bacterias o los anaerobios han perdido su actividad después del contacto con detergentes, agentes que contienen cloro.
Por todas las razones anteriores, no se excluye la probabilidad de un tanque de producción de solo un tanque séptico instalado (los profesionales deben confiar en la instalación del equipo).
4 razones para la aparición de un olor de un tanque séptico - en el video:
¿Cómo eliminar el olor?
Dependiendo de la causa establecida del olor desagradable, se selecciona una cierta forma de eliminar el problema.
Limpiar el contenedor
Solo hay una forma de eliminar el olor de un tanque séptico desbordado: limpiando el contenedor de recolección. Este proceso se puede realizar manualmente o con equipo especializado.
La limpieza manual se realiza de acuerdo con el siguiente algoritmo:
 los desechos líquidos se eliminan del pozo con un balde o bomba de drenaje;
los desechos líquidos se eliminan del pozo con un balde o bomba de drenaje;- una pala elimina los depósitos sólidos del fondo del pozo negro;
- la superficie interior del tanque de almacenamiento se limpia con un cepillo de hierro;
- se usa agua corriente de una manguera para enjuagar el tanque séptico (el recipiente se llena con agua durante diez minutos, después de lo cual se bombea el líquido).
Para aquellos que no tienen el deseo, la oportunidad y el tiempo de limpiar manualmente el tanque séptico, los especialistas acudirán al rescate. En Internet hay un número suficiente de teléfonos de empresas especializadas en bombear y retirar los residuos acumulados de un pozo negro.
A su llegada, el especialista baja la manguera de la máquina - bomba de lodos en el tanque de almacenamiento... Una bomba de vacío levanta los desechos con inclusiones sólidas desde una gran profundidad y, a través de una manguera, los transfiere a un tanque de almacenamiento especial para su posterior transporte y eliminación.
Ventilación
La construcción de una tubería de desagüe ayuda a eliminar los gases acumulados de las aguas residuales, reduce la formación de olores desagradables. Además, debido al suministro constante de oxígeno dentro de la planta de tratamiento, las bacterias (limpiadores de fosas sépticas) comienzan a trabajar de manera más activa.
La construcción del elevador de ventilación se lleva a cabo de acuerdo con el siguiente esquema:
- Preparación de material. Para el trabajo, necesita una tubería de plástico (diámetro 110 mm), sujetadores (abrazadera, soporte), sellador, una punta que proteja el dispositivo de la precipitación y la contaminación externa.
- La tubería se coloca en un tanque séptico.
- Las juntas se sellan cuidadosamente con un sellador.
- La parte superior de la tubería está cubierta con una tapa protectora.
Según los documentos reglamentarios, para casas privadas de dos pisos, la instalación de una tubería de ventilador es obligatoria.
Bacterias: ¿cómo funciona?
El uso de productos biológicos especiales ayuda a resolver varios problemas a la vez:
El uso de productos biológicos especiales ayuda a resolver varios problemas a la vez:
- eliminar el olor desagradable,
- reducir el volumen del relleno del tanque séptico,
- desinfectar las superficies del tanque de almacenamiento.
Las bacterias son absolutamente seguras para las personas y el medio ambiente. La sustancia formada durante la interacción de las bacterias con los desechos humanos se puede utilizar como fertilizante.
Para hacer la elección correcta de un producto biológico, debe prestar atención a los siguientes puntos:
- los microorganismos en mezclas líquidas están inmediatamente listos para trabajar, las composiciones secas y granulares requieren manipulaciones especiales para "despertar" las bacterias;
- cuanto mayor sea la concentración de bacterias en la preparación, mayor será la eficiencia de su trabajo;
- la relación entre el número de bacterias y el volumen de los desechos de la fosa séptica (con una falta de bacterias, no habrá una limpieza efectiva, una cantidad excesiva también es ineficaz, ya que en este caso las bacterias se devorarán a sí mismas).
Es muy importante controlar la fecha de caducidad del producto biológico. Las formulaciones frescas son más efectivas.
El video contará sobre bacterias para fosas sépticas:
Prevención
Olvidar el problema del olor desagradable de un tanque séptico en una casa honesta para siempre, debe ocuparse de los siguientes puntos:
- En la etapa de diseño, elija tanques sépticos volumétricos (es mejor instalar uno más grande que sufrir los olores desagradables de un tanque constantemente sobrellenado).
- Aborde con cuidado la elección de bacterias para un tanque séptico (la mejor opción son las formulaciones con bacterias anaeróbicas que funcionan activamente sin un suministro constante de oxígeno).
- Limpieza periódica del tanque de almacenamiento (ayuda a evitar olores desagradables).
Antes de comprar un tanque séptico, debe verificar cada detalle, estanqueidad y materiales de fabricación. La calidad del funcionamiento de la unidad en el futuro depende de esto.
Consejo
Recomendaciones de propietarios de casas privadas con experiencia acelerar el proceso de eliminación del olor desagradable del tanque séptico:
 Al limpiar, no se olvide del equipo de protección personal. Los guantes de goma, un respirador, una bata vieja y un delantal de goma ayudarán a evitar que la materia fecal entre en contacto con la piel.
Al limpiar, no se olvide del equipo de protección personal. Los guantes de goma, un respirador, una bata vieja y un delantal de goma ayudarán a evitar que la materia fecal entre en contacto con la piel.- Después de la limpieza, queda una cierta cantidad de líquido en el tanque séptico, que debe bombearse con una bomba convencional. No se recomienda utilizar un filtro (existe un alto riesgo de obstrucción del equipo).
- Está prohibido bombear desechos simplemente al suelo (existen grandes riesgos de contaminación del suelo y las aguas subterráneas en el sitio). El contenido del pozo negro se recoge en barriles de plástico, que se llevan a estaciones especiales para el procesamiento de residuos.
El estricto cumplimiento de las instrucciones del fabricante para operar el tanque séptico ayudará a minimizar los riesgos de olores desagradables.
Encontrará mucha información útil e importante sobre cómo eliminar varios olores desagradables de objetos y superficies en esta sección.
Conclusión
Un olor desagradable de un tanque séptico no es motivo de pánico. Utilizando en la práctica numerosas formas de resolver este problema, puede eliminarlo rápidamente, sin mucho esfuerzo.


